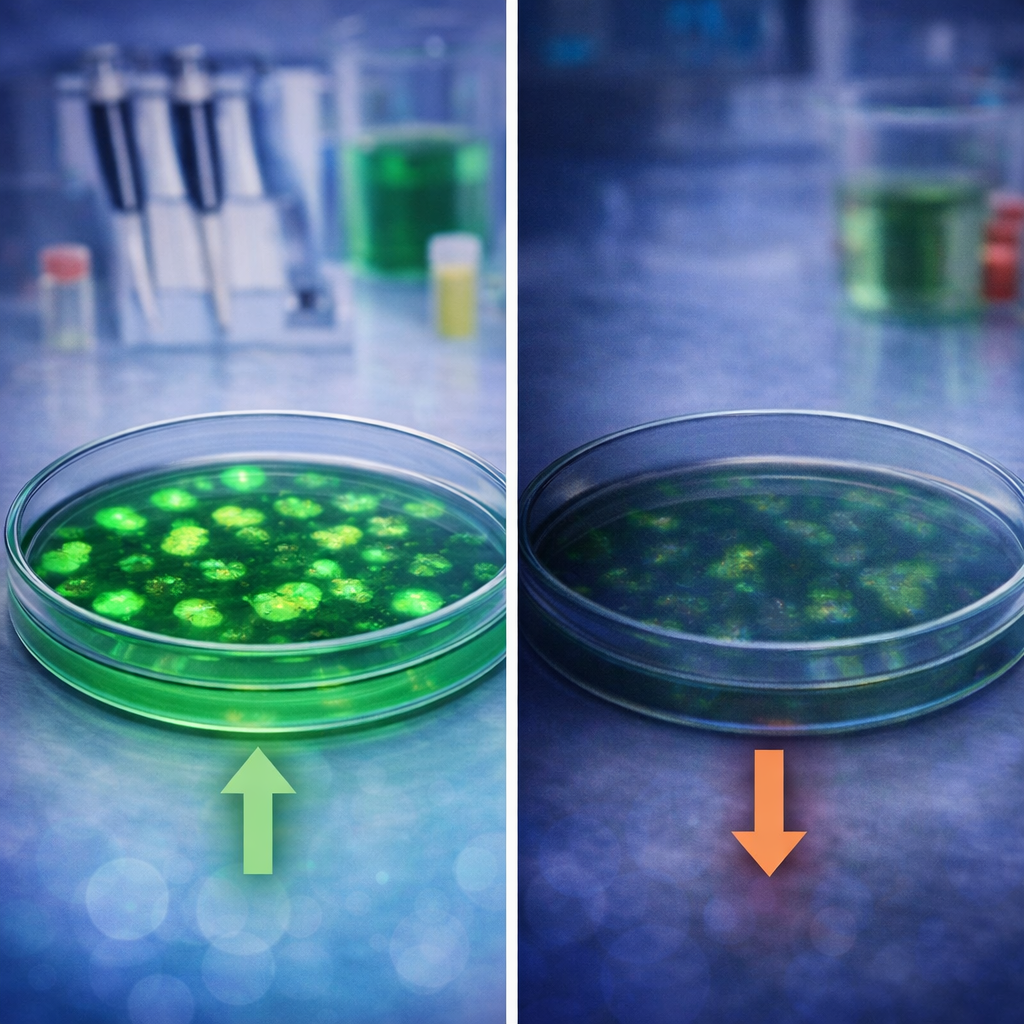
light source not working

5 Common Fluorescence Imaging Problems That Are Actually Illumination Problems
When fluorescence imaging goes a bit wrong, the first instinct is usually to blame the sample.
Or the staining.
Or the filters.
Or, if the day has been especially unkind, the entire microscope and possibly modern science itself.
And fair enough.
But sometimes the problem isn’t the sample, the prep or the operator. Sometimes it’s the light source quietly causing trouble in the background like an office colleague who never does anything dramatic, but somehow still manages to make your day more annoying than it should be.
1. My results look slightly different every time
This one’s a classic. Nothing looks wildly wrong, but your images don’t feel quite as consistent as they should.
That can happen when the illumination isn’t stable and repeatable. If the light output shifts, it gets harder to tell whether changes are coming from the sample or the system.
A stable LED light source helps take one more variable out of the equation – which is handy, because all of our light sources are designed for stable, repeatable performance with precise irradiance control, which helps keep imaging conditions more consistent over time.


2. Switching between channels feels slow and clunky
You want to move between channels quickly. Your sample would also quite like that.
If switching is sluggish, awkward or overcomplicated, multi-channel imaging starts feeling like more of a chore than it needs to. That’s especially unhelpful when you’re working with live or changing samples.
Luckily for you, some of our products like the pE-400max supports high-speed imaging with under 10 microsecond TTL triggering, while the pE-800 offers eight individually controllable LEDs and sub 7 microsecond switching for more demanding workflows. In short: less faffing, more imaging.
3. My images look muddier than they should
If you’re seeing more background than you’d like, illumination could be part of the problem.
Poor wavelength control can make it harder to target exactly what you want, which means the image can end up looking less clean and less crisp than it ought to.
That’s where tighter control helps and, as it so happens, a lot of our Illumination Systems are designed for individual wavelength control and precise irradiance adjustment, which can help reduce background and keep things cleaner. Sometimes the answer isn’t more light. It’s better-behaved light.

4. My light source doesn’t really fit the way we actually work
Sometimes the microscope is still perfectly good, it’s just the illumination setup that’s no longer keeping up.
Maybe the workflow’s changed. Maybe the applications have moved on. Maybe different users need something quicker or easier to control. These things happen.
For everyday fluorescence, the pE-300 Series is designed to cover a wide range of common applications. For more advanced or multi-channel work, the pE-400max, pE-800, or pE-4000 offer more control and flexibility without turning the whole process into a science project.
5. We need to move on from mercury, but not create a headache
A lot of labs know they now need to move away from traditional mercury or metal-halide systems – they don’t really have a choice anymore – but that doesn’t mean they want to make everyday imaging more complicated.
Usually, what people want is something safer, simpler and easier to live with. A light source that just gets on with it.
That’s part of the appeal of LED upgrades. Our pE-300lite and pE-300white are both positioned as mercury-free alternatives for routine fluorescence microscopy, with spectral coverage from DAPI to Cy5. A practical upgrade, without the unnecessary drama.

Sometimes it really is the light source
Illumination isn’t always the first thing people suspect. But it has a habit of causing problems quietly.
Get it right, though, and a lot of things get easier. Results feel more consistent. Switching gets quicker. Imaging becomes less of a battle.
Which is really the whole point. You’ve got enough going on already.
Written by Ben Furness / [email protected] / LinkedIn Profile






